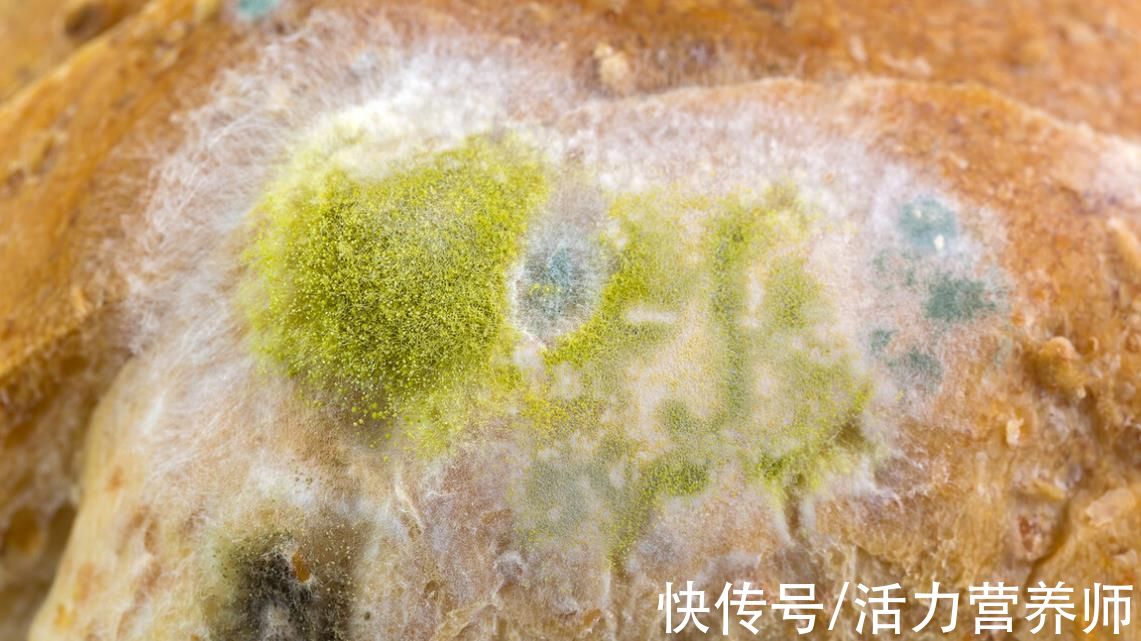
患者|全球肝癌患者多在我国,营养师发出提醒:这几种食物要管住嘴了

患者|全球肝癌患者多在我国,营养师发出提醒:这几种食物要管住嘴了
你知道肝癌吗?所谓不知者无畏,不要再认为肝癌离我们很远了,要知道我国因肝癌死亡的人每年都在更新,甚至死亡人数可以和发病人数相比。

文章插图
如今,已经成长为可以导致全民死亡的第二大癌症,几乎在每8个因癌症去世的人,都有可能因为1人死于肝癌,男性要远大于女性。
这也应了那句话——癌从口入,也并非没有道理。在这里营养师发出提醒:为了保护肝脏的健康,这几种食物要管住嘴。

文章插图
【 患者|全球肝癌患者多在我国,营养师发出提醒:这几种食物要管住嘴了】第一种是发霉食物,这类食物最关键的是一种叫做黄曲霉毒素的致癌物,这种致癌物被世界卫生组织下属的国际癌症机构列为1类致癌物,即最严重的类别,对肝脏有明显的危害。
黄曲霉毒素是什么厉害的角色?
还别说危害性很大,它是黄曲霉菌群的一种,当食物感染该毒素后,会出现明显的黄色或者是黄绿色。由于它有温度限定,非常适合在30~39摄氏度中生存。
文章插图
即使很小的量也容易危及身体健康,根据中国科学院微生物研究所指出,黄曲霉毒素的毒性是氰化钾的10倍、砒霜的68倍,一旦接触1mg也容易诱发癌症,接触得越多危害性越大。
根据黄曲霉毒素极易感染的食物,都是大家需要格外关注的,有花生、大米、玉米、馒头、面包等。此外,大家还要注意冰箱等容易藏污纳垢的地方,由于湿度符合条件,也有可能感染黄曲霉毒素。

文章插图
如果大家在买食物时,发现有这种现象,还可以及时退回,如果家里的任何食物有发霉迹象,切记不能把发霉的地方去掉后继续食用,以扔掉为主。
如果一个袋子里有任何食物发霉,剩下的食物都最好不吃了。对于不小心进食到黄曲霉毒素的食物,稍有不适及时去医院检查,避免病情出现恶化。

文章插图
第二种酒精,酒精和肝脏的关系很密切,当酒进入肝脏后,肝脏需要解毒,而酒精在代谢过程中还会产生对肝脏危害的乙醛,一旦过量沉积,当肝组织发生炎症坏死,诱发肝炎,如此还继续喝酒,还会接着恶化,再到肝硬化,甚至是肝癌。
如果你已经患上酒精性脂肪肝不能忽视,尽早配合医生,并且要做到定期检查,避免长期如此诱发肝癌。在这种情况下,建议你一口酒都不要喝,才能为身体保驾护航。
- 脂肪肝患者|脂肪肝能不药而愈?关于脂肪肝,这4个错误认知要避免
- 全球疫情|今天凌晨,海珠通知
- 心脑血管|大荔中医医院脾胃肺病科“妙手回春”受到患者的称赞
- 救治|丨绿色通道丨多学科通力合作抢救无保护左主干前壁心梗患者
- 常崇旺|【视频回放】脑瘫患者常用外科术式及适应症
- 运动神经元患者案例分享
- 人工心脏|山东首例人工心脏植入患者出院,需每天充电
- 守护|温暖“疫”线 | 迎难而上加班加点,医大二院全力守护透析患者“生命线”
- 香港|广州复大肿瘤医院案例966:香港胰腺癌患者赴广州就医重获新生
- 救治|全国首例!国产ECMO在阜外医院成功救治一名患者
